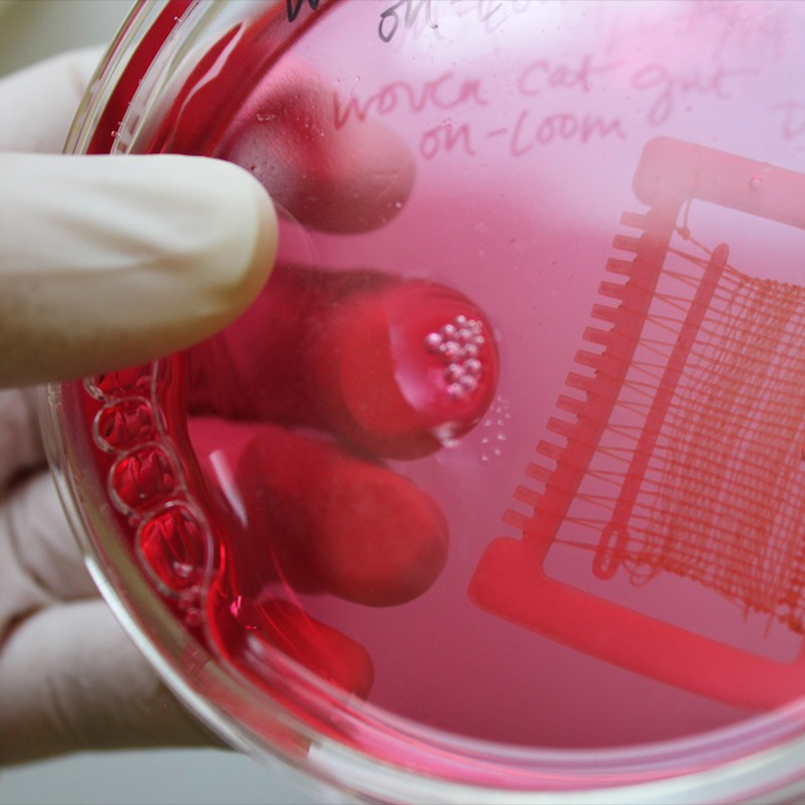

Montréalaise d’adoption, la canadienne WhiteFeather Hunter a plusieurs cordes à son arc : artiste, chercheure, enseignante, consultante et écrivaine. Depuis quinze ans, elle s’adonne professionnellement au bioart. Fondée sur l’artisanat, sa pratique s’appuie de fait sur l’analyse matérielle du potentiel artistique, fonctionnel et technologique des matières corporelles. Son œuvre se déploie tous azimuts : de l’utilisation de cheveux aux fins de techniques textiles traditionnelles, au recours à une taxidermie à l’état brut dans la confection de sculptures en lambeaux de chair et fragments d’os trouvés, en passant par des représentations – inspirées par les cultures pop ou numérique – d’un corps absent de l’univers technologique.